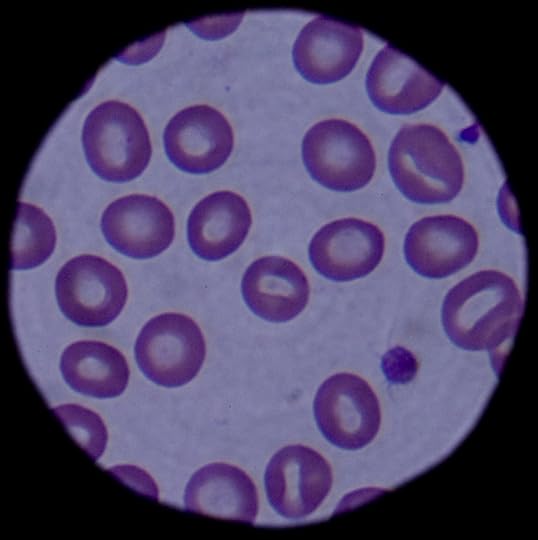

Scott GK MacLeod's Blog, page 81
January 2, 2020
Artemisia tridentata: Optimism about crisis of global climate change from Harvard Professor Jim McCarthy, Longevity and age reversal from Joi Ito and about Harvard and much about MIT Professor of Genetics George Church * * * Exercise and meditation in add
Ma,
Warm greetings from St. Louis MO Airport. Flight from Pgh went well. And Christmas and New Year's were wonderful, Ma! - I feel I'm so fortunate you're my mother! Thank you. ... Let's stay in touch about this further, Ma! When's your next Unitarian Universalist choir practice?
Found a mini strap in the duffel's pocket which should attach it to wheeled suitcase for walk back in Berkeley from train. Flight should be 4:45 minutes' long, and get in on time at 4:25pm ... good schedule.
Seeking to find the article about the seriousness of global warming from Harvard in my blog from 2018 https://news.harvard.edu/gazette/story/2018/02/harvards-james-mccarthy-honored-for-climate-change-insights/ from http://scott-macleod.blogspot.com/2018/07/sailing-to-penikese-island.html (and other posts) to post in 1/1/20 blog entry ... https://scott-macleod.blogspot.com/2020/01/quaking-aspen-populus-tremuloides.html
And re longevity and age-reversal from Joi Ito and about Harvard and much about MIT Professor of Genetics George Church https://web.archive.org/web/20180605002848/https://www.wired.com/story/the-responsibility-of-immortality/ from https://scott-macleod.blogspot.com/2019/06/montane-ecosystems-longevity.html in 12/31/19 blog post - https://scott-macleod.blogspot.com/2019/12/wild-pomegranate-burchellia-bubalina.html ... :)
I think I agree with you that exercise and meditation in addition to 5-10 servings of fruits, vegetables, grains, and legumes with lots of bright green vegetables (for anti-oxidants plus) are great for health, and the bodymind! What else? :))
How's your day going?
L, Scott
*
SCIENCE & TECHNOLOGY James McCarthy recognized for climate change insightsTyler Prize winner sees hope for confronting growing threats in researchers of tomorrow
SCIENCE & TECHNOLOGYJames McCarthy recognized for climate change insights
https://news.harvard.edu/gazette/story/2018/02/harvards-james-mccarthy-honored-for-climate-change-insights/
*
Gull: Sailing to Penikese Island, Glad Harvard Prof Jim McCarthy thinks climate change / global warming is manageable albeit still a ginormous problem (access article from here), Historical_Societies_Open_Teaching_and_Learning_Resources at WUaS- http://scott-macleod.blogspot.com/2018/07/sailing-to-penikese-island.html -
* Quaking Aspen (Populus tremuloides): Reversing global warming conversation online and re science & treaties (and the coal belt ... as well as re jobs!) * Beginnings of the "Ocean & Climate Management Plan" at wiki best STEM CC-4 OCW-centric World Univ & Sch - https://wiki.worlduniversityandschool.org/wiki/Ocean_%26_Climate_Management_Plan . . . At present there are 6 planned majors at WUaS for free-to-students' Bachelor's online degrees - worlduniversityandschool.org - and some of the above MIT OCW courses could be studied as part of the General Science degree- https://scott-macleod.blogspot.com/2020/01/quaking-aspen-populus-tremuloides.html -
* *
THE RESPONSIBILITY OF IMMORTALITY: WELCOME TO THE NEW TRANSHUMANISMTHE RESPONSIBILITY OF IMMORTALITY: WELCOME TO THE NEW TRANSHUMANISM
- https://web.archive.org/web/20180605002848/https://www.wired.com/story/the-responsibility-of-immortality/ -
*
Montane ecosystems: Longevity (immortality even) & where are we now with reversing aging?, MIT Media Lab Direcctor Joi Ito's "THE RESPONSIBILITY OF IMMORTALITY: WELCOME TO THE NEW TRANSHUMANISM," and "The Future of Xapiens - Xapiens at MIT was live" with Pattie Maes, Max Tegmark, David Sinclair, George Church, Ed Boyden, and Joe Paradiso * * * Dartington Hall is so very beautiful! Wonderful that you'll be teaching there together, Victor and Angela (and Satya)! * * * Hippy Anjali Yoga Notations - http://www.scottmacleod.com/yoganotations.html ! you don't say! :) How best to explore both your Yoga and creativity in online group video Hangouts newly, I wonder?- https://scott-macleod.blogspot.com/2019/06/montane-ecosystems-longevity.html -
*
Wild pomegranate (Burchellia bubalina): Season’s Greetings 2019 !
- https://scott-macleod.blogspot.com/2019/12/wild-pomegranate-burchellia-bubalina.html -
*



https://en.wikipedia.org/wiki/Artemisia_tridentata
...
Published on January 02, 2020 10:23
January 1, 2020
Quaking Aspen (Populus tremuloides): Reversing global warming conversation online and re science & treaties (and the coal belt ... as well as re jobs!) * Beginnings of the "Ocean & Climate Management Plan" at wiki best STEM CC-4 OCW-centric World Univ & Sc
Hi Alan, Christine, Jane and All,
Nice to share Christmas with you. (And thank you, Christine for Xmas!). Here's the beginning of the "Ocean & Climate Management Plan" https://wiki.worlduniversityandschool.org/wiki/Ocean_%26_Climate_Management_Plan (https://wiki.worlduniversityandschool.org/wiki/Subjects) at wiki MIT OCW-centric World Univ & Sch. Check out the 10 MIT OpenCourseWare courses here - and to see how WUaS will work as students will be able to take these or similar for credit toward free-to-students' online degrees. This wiki subject page for open teaching and learning will be in ~200 countries' official languages (https://wiki.worlduniversityandschool.org/wiki/Languages - each a wiki school in all 7,111 known living languages) too.
Explore wiki-adding your paper to this page as well under "Select References" with something like -
Yurek, Charles Alan. 2019. A “USA PLAN” for CLIMATE DEFENSE. Pittsburgh, PA: Yurek Publishing
- if you might be interested.
At present there are 6 planned majors at WUaS for free-to-students' Bachelor's online degrees - worlduniversityandschool.org - and some of the above MIT OCW courses could be studied as part of the General Science degree, for example.
Hoping all ~200 countries - https://wiki.worlduniversityandschool.org/wiki/Nation_States - each a major online MIT OCW-centric University can keep up the reverse global warming conversation online and re science & treaties (and the coal belt ... as well as re jobs!)
Happy New Year, Scott
Let's stay in touch about both of WUaS's wings - https://twitter.com/WorldUnivAndSchhttps://twitter.com/WUaSPress
@scottmacleod@sgkmacleod@HarbinBook@TheOpenBand (Berkeley)
"Tree planting 'has mind-blowing potential' to tackle climate crisis:
Research shows a trillion trees could be planted to capture huge amount of carbon dioxide"
- https://www.theguardian.com/environment/2019/jul/04/planting-billions-trees-best-tackle-climate-crisis-scientists-canopy-emissions
And in a realistic virtual earth for STEM?
searched on
'best simulations for tree plantings' potential to reverse global warming'
Examining the Viability of Planting Trees to Help Mitigate Climate Change
- https://climate.nasa.gov/news/2927/examining-the-viability-of-planting-trees-to-help-mitigate-climate-change/
*



https://en.wikipedia.org/wiki/Populus_tremuloides
https://en.wikipedia.org/wiki/Aspen
...
Published on January 01, 2020 05:43
December 31, 2019
Wild pomegranate (Burchellia bubalina): Season’s Greetings 2019 ! * * * Happy New Year LETTER
Season’s Greetings 2019!

Scott and Jane MacLeod, Christmas, Pittsburgh, Pennsylvania, 2019
Dear friends,
Happy New Year 2020! And Merry Christmas ... A Desiderata poem focus in 2020: https://mwkworks.com/desiderata.html (https://scott-macleod.blogspot.com/2019/12/antarctica-mcmurdo-bay-merry-christmas.html)?
Global university work continues daily - http://scott-macleod.blogspot.com/search/label/global%20university - with regards to wiki MIT OCW-centric World University and School. And it looks like we'll collaborate with Harvard and MIT's edX in 2020 for WUaS's 2nd class for free-to-students' CC-4 MIT OCW-centric WUaS Bachelor degrees. And glad to write I just published my 4th book "To the Dance or the Pools? ~ Virtually! How different it is to Soak at Harbin Hot Springs than to realize it in virtual Reality" (http://worlduniversityandschool.org/AcademicPress.html ~ http://amazon.com/author/scottmacleodworlduniversity) - and which I had hoped would be in Google Street View, with time slider, by the time of publication, but potentially at some point! My actual-virtual, physical-digital Harbin Hot Springs' ethnography and poetry project continues, and am hoping to write and publish a 2nd actual-virtual Harbin ethnography FROM Google Street View with time slider in the next year or two! Will create my first Scottish small pipes' album this year, as well as publish my next book of poetry in 2020 too! Still seeking a life-partner with whom to begin a family.
Happy New Year, and looking forward very much to seeing you in 2020! Here’s a poem from my new book with same name as title of book - https://scott-macleod.blogspot.com/2019/11/chameleon-vision-poem-to-dance-or-pools.html?m=0 !
Is 2020 the year of the robot (or the 2020s) - and at World University and School too? And will the 2020s be the decade for Actual-Virtual, Physical-Digital innovations, and Robot-Avatar Bot innovations too? And will we all have 'Avatar Bots' like email addresses (e.g. see the avatars in "Aphilo Scott MacLeod The Making of Virtual Harbin Introduction" -
https://youtu.be/3nhvcHw54GE) that correspond to physical robots even -
Getting ready to dance into the new year, but first, we wanted to wish educators around the world a Happy New Year! Thank you for making this year aweSTEM for your students! #HappyNewYear #NewYearsEve pic.twitter.com/SERFU3Hsef— LEGO Education (@LEGO_Education) December 31, 2019
https://twitter.com/LEGO_Education/status/1212010632981237760?s=20 - World University and School is also seeking to plan for, brainstorming-wise, coding for all 7.5 billion people for the following reasons (https://twitter.com/WorldUnivAndSch/status/1213143381011914752?s=20
https://twitter.com/scottmacleod/status/1213144260825870337?s=20).
All 7.5 billion people, each a Personal Identification Number PIN# (instead of a Wikidata Q-item # number) for:
i) wiki Universitians in 7,111 known living languages, and matriculated students in all ~200 countries,
ii) Avatar Bot Electronic Medical Records, with genetic therapies, and for molecular tele-robotic surgery, for ex.,
iii) Universal Basic Income (UBI) experiments (and to alleviate poverty), and to DISTRIBUTE a single crypto-currency backed by some number of ~200 countries' central banks (where the Euro is in 19 out of 28 EU countries, and backed by their central banks in one way or another) ... and potentially with UBI experiment recipients able, for example, to mine the "Mine Pi" crypto-currency (as a mineable single crypto-currency), developed by Stanford graduates, by clicking on the 'lightning button' brainstorming-wise.
iv) a single family tree for genealogy research as in WikiTree (https://www.wikitree.com), and for aggregating DNA samples too (see item 2 again) ... and for innovative genealogical research.
In what ways could WUaS plan in Wikdata for all 7.5 billion people each a Wikidata Q-item # and for the above reasons and many more (and keeping in sync with Wikipedia's mission of "the sum of all human knowledge" where all 7.5 billion people generate this with their language, for example)?
- https://worlduniversityandschool.blogspot.com/2019/11/minutes-for-annual-meeting-on-saturday.html
- https://scott-macleod.blogspot.com/2019/11/arabian-sand-gazelle-minutes-for-annual.html
See, too these 'longevity' blog posts here - https://scott-macleod.blogspot.com/search/label/longevity - with interesting prospects for extending life or reversing aging, beyond 122 years of age with genetic therapies.
It’s been another generative year for ideas in terms of daily blog posts - http://scott-macleod.blogspot.com - as well.
Happy New Year and best wishes to all of you and your loved ones in this holiday season!
Sincerely,Scotthttp://scottmacleod.com/http://worlduniversityandschool.org/World University and School Founder and President~ https://wiki.worlduniversityandschool.org/wiki/Nation_States (with open wiki schools in all 7,011 living languages planned) ~sgkmacleod@worlduniversityandschool.org
Scott MacLeod - https://twitter.com/scottmacleod
World Univ and Sch Twitter - http://twitter.com/WorldUnivandSch
Languages - World Univ - http://twitter.com/sgkmacleod
WUaS Press - https://twitter.com/WUaSPress
“Naked Harbin Ethnography” book (in Academic Press at WUaS) - http://twitter.com/HarbinBook
(OpenBand (Berkeley) - https://twitter.com/TheOpenBand )
~ https://scott-macleod.blogspot.com/2019/12/wild-pomegranate-burchellia-bubalina.html ~
* *
Seeking to find the article about the seriousness of global warming from Harvard in my blog from 2018 https://news.harvard.edu/gazette/story/2018/02/harvards-james-mccarthy-honored-for-climate-change-insights/ from http://scott-macleod.blogspot.com/2018/07/sailing-to-penikese-island.html (and other posts) to post in 1/1/20 blog entry ... https://scott-macleod.blogspot.com/2020/01/quaking-aspen-populus-tremuloides.html
And re longevity and age-reversal from Joi Ito and about Harvard and much about MIT Professor of Genetics George Church https://web.archive.org/web/20180605002848/https://www.wired.com/story/the-responsibility-of-immortality/ from https://scott-macleod.blogspot.com/2019/06/montane-ecosystems-longevity.html in 12/31/19 blog post - https://scott-macleod.blogspot.com/2019/12/wild-pomegranate-burchellia-bubalina.html ... :)
- https://scott-macleod.blogspot.com/2020/01/artemisia-tridentata-optimism-about.html -
*






https://en.wikipedia.org/wiki/Wild_pomegranate
https://es.wikipedia.org/wiki/Burchellia_bubalina
https://en.wikipedia.org/wiki/Burchellia
https://en.wikipedia.org/wiki/Pomegranate
...
Published on December 31, 2019 10:23
Wild pomegranate (Burchellia bubalina): Season’s Greetings 2019 !
Season’s Greetings 2019!

Scott and Jane MacLeod, Christmas, Pittsburgh, Pennsylvania, 2019
Dear friends,
Happy New Year 2020! And Merry Christmas ... A Desiderata poem focus in 2020: https://mwkworks.com/desiderata.html (https://scott-macleod.blogspot.com/2019/12/antarctica-mcmurdo-bay-merry-christmas.html)?
Global university work continues daily - http://scott-macleod.blogspot.com/search/label/global%20university - with regards to wiki MIT OCW-centric World University and School. And it looks like we'll collaborate with Harvard and MIT's edX in 2020 for WUaS's 2nd class for free-to-students' CC-4 MIT OCW-centric WUaS Bachelor degrees. And glad to write I just published my 4th book "To the Dance or the Pools? ~ Virtually! How different it is to Soak at Harbin Hot Springs than to realize it in virtual Reality" (http://worlduniversityandschool.org/AcademicPress.html ~ http://amazon.com/author/scottmacleodworlduniversity) - and which I had hoped would be in Google Street View, with time slider, by the time of publication, but potentially at some point! My actual-virtual, physical-digital Harbin Hot Springs' ethnography and poetry project continues, and am hoping to write and publish a 2nd actual-virtual Harbin ethnography FROM Google Street View with time slider in the next year or two! Will create my first Scottish small pipes' album this year, as well as publish my next book of poetry in 2020 too! Still seeking a life-partner with whom to begin a family.
Happy New Year, and looking forward very much to seeing you in 2020! Here’s a poem from my new book with same name as title of book - https://scott-macleod.blogspot.com/2019/11/chameleon-vision-poem-to-dance-or-pools.html?m=0 !
Is 2020 the year of the robot (or the 2020s) - and at World University and School too? And will the 2020s be the decade for Actual-Virtual, Physical-Digital innovations, and Robot-Avatar Bot innovations too? And will we all have 'Avatar Bots' like email addresses (e.g. see the avatars in "Aphilo Scott MacLeod The Making of Virtual Harbin Introduction" - https://youtu.be/3nhvcHw54GE) that correspond to physical robots even - and conceptually with robots that we can first make in Lego Robotics' WeDo 2.0, Mindstorms EV3, and Lego Spike Prime Robotics, and then in Google Street View with time slider / with Brick Street View for robotics design? I'd chance to make these predictions.
World University and School is also seeking to plan for, brainstorming-wise, coding for all 7.5 billion people for the following reasons.
All 7.5 billion people, each a Personal Identification Number PIN# (instead of a Wikidata Q-item # number) for:
i) wiki Universitians in 7,111 known living languages, and matriculated students in all ~200 countries,
ii) Avatar Bot Electronic Medical Records, with genetic therapies, and for molecular tele-robotic surgery, for ex.,
iii) Universal Basic Income (UBI) experiments (and to alleviate poverty), and to DISTRIBUTE a single crypto-currency backed by some number of ~200 countries' central banks (where the Euro is in 19 out of 28 EU countries, and backed by their central banks in one way or another) ... and potentially with UBI experiment recipients able, for example, to mine the "Mine Pi" crypto-currency (as a mineable single crypto-currency), developed by Stanford graduates, by clicking on the 'lightning button' brainstorming-wise.
iv) a single family tree for genealogy research as in WikiTree (https://www.wikitree.com), and for aggregating DNA samples too (see item 2 again) ... and for innovative genealogical research.
In what ways could WUaS plan in Wikdata for all 7.5 billion people each a Wikidata Q-item # and for the above reasons and many more (and keeping in sync with Wikipedia's mission of "the sum of all human knowledge" where all 7.5 billion people generate this with their language, for example)?
- https://worlduniversityandschool.blogspot.com/2019/11/minutes-for-annual-meeting-on-saturday.html
- https://scott-macleod.blogspot.com/2019/11/arabian-sand-gazelle-minutes-for-annual.html
See, too these 'longevity' blog posts here - https://scott-macleod.blogspot.com/search/label/longevity - with interesting prospects for extending life or reversing aging, beyond 122 years of age with genetic therapies.
It’s been another generative year for ideas in terms of daily blog posts - http://scott-macleod.blogspot.com - as well.
Happy New Year and best wishes to all of you and your loved ones in this holiday season!
Sincerely,Scotthttp://scottmacleod.com/http://worlduniversityandschool.org/World University and School Founder and President~ https://wiki.worlduniversityandschool.org/wiki/Nation_States (with open wiki schools in all 7,011 living languages planned) ~sgkmacleod@worlduniversityandschool.org
Scott MacLeod - https://twitter.com/scottmacleod
World Univ and Sch Twitter - http://twitter.com/WorldUnivandSch
Languages - World Univ - http://twitter.com/sgkmacleod
WUaS Press - https://twitter.com/WUaSPress
“Naked Harbin Ethnography” book (in Academic Press at WUaS) - http://twitter.com/HarbinBook
(OpenBand (Berkeley) - https://twitter.com/TheOpenBand )
~ https://scott-macleod.blogspot.com/2019/12/wild-pomegranate-burchellia-bubalina.html ~
*






https://en.wikipedia.org/wiki/Wild_pomegranate
https://es.wikipedia.org/wiki/Burchellia_bubalina
https://en.wikipedia.org/wiki/Burchellia
https://en.wikipedia.org/wiki/Pomegranate
...
Published on December 31, 2019 10:23
December 30, 2019
Rosa persica: WUaS News Q&A #WorldUnivAndSchNewsQandA newly in #LightStream > http://youtube.com/WorldUnivandSch Mon 12/30/19 at 10a PT Topic: Your Questions / ideas @WorldUnivAndSch & @WUaSPress online Universities in https://wiki.worlduniversityandschool
Couldn't LiveStream earlier today about ...
- https://scott-macleod.blogspot.com/2019/12/chinese-elm-ulmus-parvifolia-these-22.html -
Chinese elm (Ulmus Parvifolia): These 22 million WikiTree profiles - and re WUaS Wikidata Q-item3s or related PIN# * The author Douglas Adams' Wikidata Q item # - https://m.wikidata.org/wiki/Q42 - as WikiTree profile is the idea, - at WUaS too ...
Chinese elm (Ulmus Parvifolia): These 22 million WikiTree profiles - and re WUaS Wikidata Q-item3s or related PIN# * The author Douglas Adams' Wikidata Q item # - https://m.wikidata.org/wiki/Q42 - as WikiTree profile is the idea, - at WUaS too- https://scott-macleod.blogspot.com/2019/12/chinese-elm-ulmus-parvifolia-these-22.html -
*
See ...
WUaS - World University and School <worlduniversityandschool@gmail.com>1:10 PM (2 hours ago)



Peter and Drew, suggestions? Here are some of the error messages:
Your YouTube account must be enabled for live streaming before broadcasting.
Fix It
Failed to start broadcast
Failed to authenticate YouTube for World University and School.
... from both Light Stream and YouTube ...
Will try again in 2020, and on next Monday 6 January, 2019 at 10 am PT.
Happy New Year!Scott
- https://twitter.com/WorldUnivAndSch- https://twitter.com/WUaSPress
World Univ & Sch 30 Dec 2019 Q & A and News
* *
WUaS News Q&A #WorldUnivAndSchNewsQandA newly in #LightStream > http://youtube.com/WorldUnivandSch Mon 12/30/19 at 10a PT Topic: Your Questions / ideas
@WorldUnivAndSch & @WUaSPress online Universities in https://wiki.worlduniversityandschool.org/wiki/Nation_States @ScottMacLeod info@ http://worlduniversityandschool.org to join
WUaS News Q&A #WorldUnivAndSchNewsQandA newly in #LightStream >http://youtube. com/WorldUnivandSch Mon 12/30/19 at 10a PT Topic: Your Questions / ideas@WorldUnivAndSch & @WUaSPress online Universities in https://t.co/LRKdU7tOTE @ScottMacLeod info@ https://t.co/N22UccIVou to join— WorldUnivandSch (@WorldUnivAndSch) December 30, 2019
https://twitter.com/WorldUnivAndSch/status/1211658021765623809?s=20
https://twitter.com/sgkmacleod/status/1211674360773263360?s=20
https://twitter.com/WUaSPress/status/1211674538880241664?s=20
https://twitter.com/HarbinBook/status/1211675653604626433?s=20
https://twitter.com/scottmacleod/status/1211676394603909121?s=20
https://twitter.com/TheOpenBand/status/1211676606768570369?s=20
*
WUaS - World University and School <worlduniversityandschool@gmail.com>9:40 AM (1 hour ago)



Come join the conversation. I'm going to LightStream a World Univ & Sch News and Q & A at 10 am PT / 6:00 PM Monday, Coordinated Universal Time (UTC) or 1800 UTC, and via a Livestream too - https://www.youtube.com/user/WorldUnivandSch.
Having just noticed Ajit's Tweet from West Bengal, India -
#IndiaSupportsCAA कुछ जोकर लोग ये कहते हैं कि CAA और NPR जनता पर टैक्स है, कल यही लोग कहेंगे की इंडियन आर्मी, इंडियन पुलिस, इसरो जैसी संस्था जनता पर टैक्स है और जनता की गाढ़ी कमाई को बर्बाद कर रही है. हद है जोकरई की. @ZeeNews @ABPNews @ndtv @indiatvnews @aajtak— Ajit Mishra (CMILT) (@ajitmishra71) December 30, 2019- https://twitter.com/ajitmishra71/status/1211653644593975299?s=20 - am wondering how best to LightStream these videos in Bengali and Hindi and your languages as well! Peter in German?
WUaS News Q&A #WorldUnivAndSchNewsQandA newly in #LightStream >http://youtube. com/WorldUnivandSch Mon 12/30/19 at 10a PT Topic: Your Questions / ideas
@WorldUnivAndSch & @WUaSPress online Universities in https://wiki.worlduniversityandschool.org/wiki/Nation_States @ScottMacLeod info@ http://worlduniversityandschool.org to join
WUaS News Q&A #WorldUnivAndSchNewsQandA newly in #LightStream >http://youtube. com/WorldUnivandSch Mon 12/30/19 at 10a PT Topic: Your Questions / ideas@WorldUnivAndSch & @WUaSPress online Universities in https://t.co/BTiP3J2DrW @ScottMacLeod info@ https://t.co/PxbdiQn0CK to join— Languages-World Univ (@sgkmacleod) December 30, 2019- https://twitter.com/sgkmacleod/status/1211674360773263360?s=20 - - https://twitter.com/WorldUnivAndSch/status/1211658021765623809?s=20 -
World Univ & Sch cheers, Scott- https://twitter.com/WorldUnivAndSch
*
! @WorldUnivandSch Mon 12/30/19 at 1pm ET, 10am PT Topic: Your Questions / ideas @WorldUnivAndSch & @WUaSPress online Universities in ~200 https://wiki.worlduniversityandschool.org/wiki/Nation_States' Langs email @ScottMacLeod info@ http://worlduniversityandschool.org to join
#WorldUnivAndSchNewsQandA http://scott-macleod.blogspot.com/2019/12/rosa-persica-wuas-news-q.html -
! @WorldUnivandSch Mon 12/30/19 at 1pm ET, 10am PT Topic: Your Questions / ideas @WorldUnivAndSch & @WUaSPress online Universities in ~200 https://t.co/tl6R7zlUi9' Langs email @ScottMacLeod info@ https://t.co/m36MJTIdkY to join#WorldUnivAndSchNewsQandA https://t.co/DjcVw8jVfH -— ScottMacLeod (@scottmacleod) December 30, 2019
- https://twitter.com/scottmacleod/status/1211684615041298433?s=20
- https://twitter.com/WorldUnivAndSch/status/1211684969485152259?s=20
- https://twitter.com/WUaSPress/status/1211685171927429120?s=20
- https://twitter.com/sgkmacleod/status/1211685322951741440?s=20
*
World Univ & Sch's Live Stream begins in about 20 minutes:
http://scott-macleod.blogspot.com/2019/12/rosa-persica-wuas-news-q.html
Come join the conversation in Light Stream - https://studio.golightstream.com/. I'm going to try to LightStream a Monday 30 Dec 2019 World Univ & Sch News and Q & A at 10 am PT / 1 pm Eastern Time / 6:00 PM Coordinated Universal Time (UTC) or 1800 UTC, and via a Livestream too - https://www.youtube.com/user/WorldUnivandSch.
Cheers, Scott
- https://twitter.com/WorldUnivAndSch- https://twitter.com/WUaSPress
World Univ & Sch 30 Dec 2019 Q & A and News
*



https://en.wikipedia.org/wiki/Rosa_persica
https://war.wikipedia.org/wiki/Rosa_persica
...
Published on December 30, 2019 07:59
December 29, 2019
Rose of Provins (Rosa gallica): In what ways was NASA influenced by hippies in the 1960s and '70s, and related social movements ... especially with putting people on the moon in 1969, and with, for ex. Maggie Hamilton (who went to Quaker Earlham College, b
Hi Kris, (and Hugh),
Very nice to meet and talk with you on Christmas Eve at the Unitarian church in Pittsburgh. How is your trip to North Carolina going? I'm also writing to let you know about this Virtual Choir wiki subject at MIT OCW-centric wiki World University and School - https://wiki.worlduniversityandschool.org/wiki/Virtual_Choir - for open teaching and learning, and which I'm developing. World Univ & Sch would like to facilitate online choirs and music-making in real, real time, as well as much else musically :) - https://wiki.worlduniversityandschool.org/wiki/World_University_Music_School. (I've sung in the 1st UU choir of Pgh in 2006-2007, and in the Unitarian Universalist Choir of Palo Alto's choir about 2 years ago for a semester, which is near Stanford). It would be great to explore World Univ & Sch ONLINE musical develops further.
At Betsy's suggestion, I'm writing to ask if you could possibly please share A's contact information. I've invited Betsy and A. to New Year's Eve, and Betsy doesn't seem to have access to A’s info. I'd also like to inquire with A. about win-win language learning opportunities; re becoming pen-pals or for video-language-exchanges - since I'd like to explore improving my German speaking, listening, writing and reading). Thank you!
Happy New Year!
Musical regards, Scott
e.g. see:- https://wiki.worlduniversityandschool.org/wiki/Piano( - https://wiki.worlduniversityandschool.org/wiki/Subjects )
- https://www.first-unitarian-pgh.org/our-staff.html
Hugh, here are the beginnings of online Law Schools at WUaS - https://wiki.worlduniversityandschool.org/wiki/World_University_Law_School
Law Schools at World University and School (planned in main languages in them)Afghanistan Law School at WUaS: https://wiki.worlduniversityandschool.org/wiki/Afghanistan_Law_School_at_WUaSBrazil Law School at WUaS: https://wiki.worlduniversityandschool.org/wiki/Brazil_Law_School_at_WUaSChina Law School at WUaS: https://wiki.worlduniversityandschool.org/wiki/China_Law_School_at_WUaSEgypt Law School at WUaS: https://wiki.worlduniversityandschool.org/wiki/Egypt_Law_School_at_WUaSIndia Law School at WUaS: https://wiki.worlduniversityandschool.org/wiki/India_Law_School_at_WUaSJamaica Law School at WUaS: https://wiki.worlduniversityandschool.org/wiki/Jamaica_Law_School_at_WUaSMexico Law School at WUaS: https://wiki.worlduniversityandschool.org/wiki/Mexico_Law_School_at_WUaSWorld University Law School: https://wiki.worlduniversityandschool.org/wiki/World_University_Law_School
Cheers, Scott- https://www.amazon.com/author/scottmacleodworlduniversity~ http://tinyurl.com/p62rpcg ~ https://twitter.com/HarbinBook ~ http://bit.ly/HarbinBook ~
* * *
In what ways was NASA influenced by hippies in the 1960s and '70s, and related social movements ... especially with putting people on the moon in 1969, and with, for ex. Maggie Hamilton (who went to Quaker Earlham College, before MIT)? And what were the influences of the 1960s and 1970s re hippies on NASA as a space organization, especially with regard to innovation and creativity? ... and with regard to chain of command questions, and so much more in a related vein ... * People landing on the moon in 1969 * * * Manuel Castells on the Information Technology Revolution and implications for peace ...
- https://www.nasa.gov/audience/forstudents/k-4/stories/first-person-on-moon.html
- https://www.history.com/topics/space-exploration/moon-landing-1969
- https://www.nasa.gov/mission_pages/apollo/apollo11.html
*




https://en.wikipedia.org/wiki/Rosa_gallica
...
Published on December 29, 2019 13:12
December 28, 2019
Chinese elm (Ulmus Parvifolia): These 22 million WikiTree profiles - and re WUaS Wikidata Q-item3s or related PIN# * The author Douglas Adams' Wikidata Q item # - https://m.wikidata.org/wiki/Q42 - as WikiTree profile is the idea, - at WUaS too
WIkiTree is 22 million profiles created by a lot of garbage GEDCOM uploads and work done of mostly retired people using an old modified Wiki 1.11.0 https://www.wikitree.com/wiki/Special:Version .... they don't have the resources to upgrade to the latest version of Wiki software....
*
An amazingly big step ... what might Lydia and WikiData say about resources, I wonder? (Is it possible to include her in this conversation, I wonder too?
*
Don't involve Lydia you can set up your own Wikibase and start playing reread the consequencies of adding bad genealogy data without sources
* https://www.wikitree.com/g2g/951698/bot-import-of-the-peerage-data-in-wikidata-good-or-bad-news
* https://www.wikidata.org/wiki/User_talk:GZWDer#User:GZWDer_(flood)_creating_duplicates
*
Thanks for the suggestion, Magnus. These 22 million Wikitree profiles may help, since World Univ & Sch's main focus is creating a Wikidata Q-item # or similar Personal Identification Number PIN# in Wikidata for our 500-2000 matriculating students in autumn 2020 and eventually for Universitians in all 200 countries and in all 7111 known living languages, and then conceptually for all 7.5 billion people, - and as WUaS makes interoperable out "front end" eg You at WUaS - https://wiki.worlduniversityandschool.org/wiki/You_at_World_University - with our Wikidata "Back end." WUaS is also seeking to plan for all 7.5 billion people, each a PIN# in Wikidata, for these 4 reasons
... iv) a single family tree for genealogy research as in WikiTree (https://www.wikitree.com, and see too World Family Tree, and for aggregating DNA samples too
- https://scott-macleod.blogspot.com/2019/12/ohio-river-if-wikitree-plans-for-single.html
iv) a single family tree for genealogy research as in WikiTree (https://www.wikitree.com ...), and for aggregating DNA samples too (see item 2 again).
In what ways could Wikdiata plan for all 7.5 billion people each a Wikidata Q-item # and for the above reasons and many more (and keeping in sync with Wikipedia's mission of "the sum of all human knowledge" where all 7.5 billion people generate this with their language, for example)?
- https://scott-macleod.blogspot.com/2019/11/arabian-sand-gazelle-minutes-for-annual.html
... so I think WUaS's strategy re these will inform engaging Wikibase. Are you a teacher of Wikibase, Magnus?
*
Why Wikidata.... you dont have one argument why they should be in WIkidata.... I hope you understand that it is Open Free data and Wikidata objects are deleted... see
Wikidata has problem scaling today and it will never be able to have 7.5 billion objects.... see Europeana objects that they copied from Wikidata and now are deleted in Wikidata but the still reference them https://phabricator.wikimedia.org/T240738
*
WUaS donated itself to Wikidata, Magnus, in 2015, and received WUaS Miraheze MediaWiki in 2017 ...
*
The author Douglas Adams' Wikidata Q item # - https://m.wikidata.org/wiki/Q42 - as WikiTree profile is the idea, - at WUaS too
*
Welcome to The Free Family Tree , growing stronger since 2008.Together we're growing an accurate single family tree using DNA and traditional genealogical sources.Privacy controls enable us to integrate modern family history.Extraordinary protections ensure that our shared tree will never be lost.Everything is 100% free including many benefits for genealogists who sign our Honor Code.Our tree includes 22,186,108 profiles (6,160,071 with DNA test connections) edited by 664,226 genealogists from around the world
Welcome to The Free Family Tree, growing stronger since 2008. Together we're growing an accurate single family tree using DNA and traditional genealogical sources. Privacy controls enable us to integrate modern family history. Extraordinary protections ensure that our shared tree will never be lost. Everything is 100% free including many benefits for genealogists who sign our Honor Code. Our tree includes 22,186,108 profiles (6,160,071 with DNA test connections) edited by 664,226 genealogists from around the world
*
- https://www.wikitree.com
*








https://en.wikipedia.org/wiki/Ulmus_parvifolia
...
Published on December 28, 2019 13:40
Chinese elm (Ulmus Parvifolia): These 22 million Wikitree profiles - and re WUaS Wikidata Q-item3s or related PIN# * The author Douglas Adams' Wikidata Q item # - https://m.wikidata.org/wiki/Q42 - as WikiTree profile is the idea, - at WUaS too
WIkiTree is 22 million profiles created by a lot of garbage GEDCOM uploads and work done of mostly retired people using an old modified Wiki 1.11.0 https://www.wikitree.com/wiki/Special:Version.... they dont have the resources to upgrade to tghe latest version of Wikisoftware....
*
An amazingly big step ... what might Lydia and WikiData say about resources, I wonder? (Is it possible to include her in this conversation, I wonder too?
*
Dont involve Lydia you can set up your own Wikibase and start playing reread the consequencies of adding bad genealogy data without sources
* https://www.wikitree.com/g2g/951698/bot-import-of-the-peerage-data-in-wikidata-good-or-bad-news
* https://www.wikidata.org/wiki/User_talk:GZWDer#User:GZWDer_(flood)_creating_duplicates
*
Thanks for the suggestion, Magnus. These 22 million Wikitree profiles may help, since World Univ & Sch's main focus is creating a Wikidata Q-item # or similar Personal Identification Number PIN# in Wikidata for our 500-2000 matriculating students in autumn 2020 and eventually for Universitians in all 200 countries and in all 7111 known living languages, and then conceptually for all 7.5 billion people, - and as WUaS makes interoperable out "front end" eg You at WUaS - https://wiki.worlduniversityandschool.org/wiki/You_at_World_University - with our Wikidata "Back end." WUaS is also seeking to plan for all 7.5 billion people, each a PIN# in Wikidata, for these 4 reasons - https://scott-macleod.blogspot.com/2019/12/ohio-river-if-wikitree-plans-for-single.html
- https://scott-macleod.blogspot.com/2019/11/arabian-sand-gazelle-minutes-for-annual.html - so I think WUaS's strategy re these will inform engaging Wikibase. Are you a teacher of Wikibase, Magnus?
*
Why Wikidata.... you dont have one argument why they should be in WIkidata.... I hope you understand that it is Open Free data and Wikidata objects are deleted... see
Wikidata has problem scaling today and it will never be able to have 7.5 billion objects.... see Europeana objects that they copied from Wikidata and now are deleted in Wikidata but the still reference them https://phabricator.wikimedia.org/T240738
*
WUaS donated itself to Wikidata, Magnus, in 2015, and received WUaS Miraheze MediaWiki in 2017 ...
*
The author Douglas Adams' Wikidata Q item # - https://m.wikidata.org/wiki/Q42 - as WikiTree profile is the idea, - at WUaS too
*








https://en.wikipedia.org/wiki/Ulmus_parvifolia
...
Published on December 28, 2019 13:40
December 27, 2019
Blood cells: AMAZING developments in treating sickle cell disease with genetic therapies ... Sickle cell anemia genetic therapy ... Simulations re Google Poly? ... 'sickle cell anemia gene therapy avatar bots computer simulations' ... "NIH researchers crea
AMAZING developments in treating sickle cell disease with genetic therapies ...
What is sickle cell disease?
Sickle cell anemia- https://www.mayoclinic.org/diseases-conditions/sickle-cell-anemia/symptoms-causes/syc-20355876
(and below)
*
It affects more than 2 million people worldwide, and about 100,000 people in the USA.
*
Braistorming-wise, in what ways in a SINGLE realistic virtual earth for STEM, for CRISPR, and with machine learning, could faculty and graduate students at World Univ and Sch and around the world, help contribute to such fascinating, and remarkable, successful genetic therapy developments as for sickle cell anemia?
And re simulations into Google Poly too?
searched on ...
'sickle cell anemia gene therapy avatar bots computer simulations' ...



* *
At World Univ & Sch ...
Genetics -
https://wiki.worlduniversityandschool.org/wiki/Genetics
Biomedical Engineering -
https://wiki.worlduniversityandschool.org/wiki/Biomedical_Engineering
Biological Engineering -
https://wiki.worlduniversityandschool.org/wiki/Biological_Engineering
* *
Computer model could help test new sickle cell drugsDate:August 22, 2019Source:Brown UniversitySummary:A new computer model that captures the dynamics of the red blood cell sickling process could help in evaluating drugs for treating sickle cell disease.https://www.sciencedaily.com/releases/2019/08/190822101423.htm
*
Computer models provide new understanding of sickle cell diseaseby Kevin Stacey, Brown University
https://phys.org/news/2017-07-sickle-cell-disease.html
* *
Sickle Cell DiseaseAlso known as Sickle Cell Anemia, Hemoglobin S or SS disease, Sickling disorder due to hemoglobin S- https://www.nhlbi.nih.gov/health-topics/sickle-cell-disease
*
Sickle cell disease
- https://ghr.nlm.nih.gov/condition/sickle-cell-disease#statistics
*
Sickle cell patient’s recovery after gene therapy heightens hopes for a cure March 12, 2019- https://www.nhlbi.nih.gov/news/2019/sickle-cell-patients-recovery-after-gene-therapy-heightens-hopes-cure -
*
Patients respond to gene therapy treatment for sickle cell anemia
https://youtu.be/qNxwq10kXXk
https://www.youtube.com/watch?v=qNxwq10kXXk
*
Gene Therapy for Sickle-Cell Anemia Looks Promising—but It’s Riddled With Controversy
By Shelly Fan - Dec 17, 2019
https://singularityhub.com/2019/12/17/gene-therapy-for-sickle-cell-anemia-looks-promising-but-its-riddled-with-controversy/
*
NIH researchers create new viral vector for improved gene therapy in sickle cell disease‘Forward-oriented’ design might boost treatment effectiveness and broaden use.- https://www.nih.gov/news-events/news-releases/nih-researchers-create-new-viral-vector-improved-gene-therapy-sickle-cell-disease
* *
Gene therapy[edit]In 2001, sickle cell disease reportedly had been successfully treated in mice using gene therapy.[125][126] The researchers used a viral vector to make the mice—which have essentially the same defect that causes human sickle cell disease—express production of fetal haemoglobin (HbF), which an individual normally ceases to produce shortly after birth. In humans, using hydroxyurea to stimulate the production of HbF has been known to temporarily alleviate sickle cell disease symptoms. The researchers demonstrated that this gene therapy method is a more permanent way to increase therapeutic HbF production.[127]Phase 1 clinical trials of gene therapy for sickle cell disease in humans were started in 2014. The clinical trials will assess the safety of lentiviral vector-modified bone marrow for adults with severe sickle cell disease.[128][129] As of 2018, however, no randomized controlled trials have been reported.[130] A case report for the first person treated was published in March 2017, with a few more people being treated since then.[131][132]Gene editing platforms like CRISPR/Cas9 have been used to correct the disease-causing mutation in hematopoietic stem cells taken from a person with the condition.[133] In July 2019 the gene-editing tool CRISPR was used to edit bone marrow cells from a person with SCD to "turning on" the gene for fetal haemoglobin.[134]
https://en.wikipedia.org/wiki/Sickle_cell_disease
* * *
Diseases Treated by Gene Therapyhttp://www.genetherapynet.com/JoomlaTest2/index.php?option=com_content&view=article&id=164:diseases-treated-with-gene-therapy-&catid=97:patient-information&Itemid=14
Biotechnology / Genetic Engineering2017 Was the Year of Gene-Therapy BreakthroughsGene-fixing treatments have now cured a number of patients with cancer and rare diseases.by Emily Mullin- https://www.technologyreview.com/s/609643/2017-was-the-year-of-gene-therapy-breakthroughs/ -
*

https://en.wikipedia.org/wiki/Blood_cell
https://en.wikipedia.org/wiki/Sickle_cell_disease
https://en.wikipedia.org/wiki/Congenital_dyserythropoietic_anemia
...
Published on December 27, 2019 05:18
December 26, 2019
Rocky Mountain National Park: Avatar bots in 2020 or 2020s? 'Avatar bots' for us - and paralleling email address - in 2020, or in the 2020s?, And for matriculating students at World Univ and Sch ... And for avatar bot electronic medical records ... but rea
'Avatar bots' for us - and paralleling email address - in 2020, or in the 2020s?
And for matriculating students at World Univ and Sch ...
And for avatar bot electronic medical records ... but realistic ....
*
Aphilo Scott MacLeod The Making of Virtual Harbin Introduction
https://youtu.be/3nhvcHw54GE
*
How do chimpanzees, common & Bonobo chimps, Orangutans, gorilla do 'troopbondage' (per John Money, Ph.D. - http://scottmacleod.com/JohnMoneyConceptsOfDeterminism.html)?
Troopbondage
"Troopbondage means bondedness among individuals so that they become members of a family or troop that continues its long-term existence despite the loss or departure of any one member. Human troopbondage has its primate phyletic origin in the fact that members of the troop breed not in unison but asynchronously, with transgenerational overlap, and with age-related interdependency. In newborn mammals, the troopbonding of a baby begins with its pairbonding with its mother as the phyletically ordained minimum unit for its survival and health. After weaning, it is also phyletically ordained for herding and troopbonding species that isolation and deprivation of the company of other members of the species or their surrogate replacements is incompatible with health and survival. Nonhuman primate species are, in the majority of instances, troopbonders like ourselves."
And with regards to the human fascination too with genealogy research in the modern world, - and which anthropologists have studied too in terms of kinship in the field in field sites, oral histories of families ... and with regards too to an ancient form of knowledge (science) generation as well?
Re Ancestry DNA and genetic tests as new family trees, and information technology tools for addressing these questions ...
*





https://en.wikipedia.org/wiki/Rocky_Mountain_National_Park...
Published on December 26, 2019 12:42